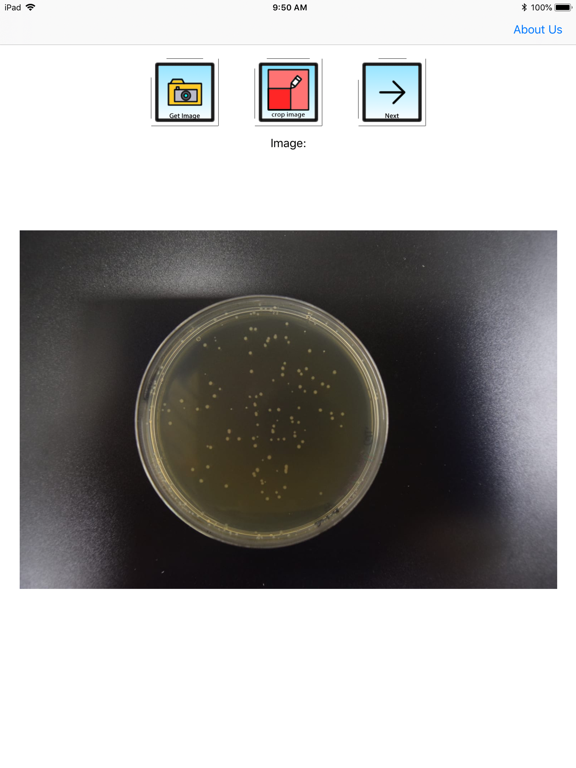
Screenshot #4 pour APD Colony Counter App PRO

APD Colony Counter App PRO
iOS Universel / Productivité
Colony counter app can analyze agar plate images and count them automatically.
With access to the phone storage, and also directly to the camera, fast and convenient colony counting can be done.
With advanced image processing methodology, even partially overlapping colonies can be detected.
With an automated colony detection with customized tagging, users can easily add or remove tags.
No need to manually count colonies or spend thousands to buy an equipment. Everything can be done now in your smartphone.
Photos should be taken on a direct plane with the agar plate.
Features of this app includes:
1) Automated colony detection
2) Adjustable image processing for users to optimize detection.
3) Advanced imaging filters: Thresholding.
4) Customized user input if necessary.
5) Saving of settings for image processing for future convenience.
6) Simple and button based user interface.
7) Compatibility with landscape and portrait view of multiple sized tablets and smartphones.
8) Compatibility with screenshot functions of analyzed images for publications or reports.
9) Tags in image can be customized for color and size.
10) Cropping function for images prior to analysis.
11) Edit function to remove or add tags.
12) Simple direct access to phone camera.
13) Simple direct access to local image.
Benefits of using this app for publications
1) Brings greater accuracy to your colony counts.
2) Value adds to publications and reports.
3) Useful teaching tool to science students.
4) Streamlined analysis, reducing human error and subjectivity - you can now trust the values reported by trainees and less experienced staff!
5) On the go analysis with the smartphone/tablet.
6) Automated analysis - no need for bulky equipment
7) The app costs less than the cheapest colony counter!
8) The app is self-contained, no internet access needed.